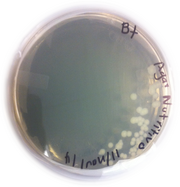

Uploads by Uriel E Barboza Perez
From OpenWetWare
Jump to navigationJump to search
This special page shows all uploaded files.
| Date | Name | Thumbnail | Size | Description |
|---|---|---|---|---|
| 02:43, 25 April 2018 | CajaRFP.jpg (file) |  |
69 KB | |
| 02:36, 25 April 2018 | Heatshock.gif (file) |  |
21 KB | |
| 07:00, 1 November 2017 | Transformacion Heatshock.png (file) |  |
70 KB | Transformación por el Método de choque termico. Imagen tomada de https://es.khanacademy.org/science/biology/biotech-dna-technology/dna-cloning-tutorial/a/bacterial-transformation-selection |
| 22:44, 25 June 2017 | UrielBarboza.jpeg (file) |  |
120 KB | |
| 22:41, 25 June 2017 | UrielBP.jpg (file) |  |
5.96 MB | Moraine Lake,Alberta |
| 00:57, 12 November 2015 | Detection-of Brucella spp. by-PCR-from-milk-samples isolated from the state of Guanajuato (file) | 950 KB | In the present study, milk samples collected from Cuerámaro, Guanajuato were analyzed by PCR assays in order to show the presence of the pathogenic Bacteria Brucella spp . Assays with attenuated vaccines containing Brucella spp., showed amplicons of ~ 20 | |
| 02:36, 26 January 2015 | R3Bt.png (file) |  |
255 KB | |
| 02:27, 26 January 2015 | R2Bt.png (file) |  |
713 KB | |
| 01:50, 26 January 2015 | R1Bt.png (file) |  |
447 KB | |
| 01:33, 26 January 2015 | PHT3101.png (file) |  |
80 KB | |
| 01:25, 26 January 2015 | El team.jpg (file) |  |
54 KB | |
| 19:36, 25 November 2014 | Resulsts1cry.png (file) |  |
279 KB | |
| 04:00, 19 November 2014 | Protocols.gif (file) | 6 KB | ||
| 06:58, 18 November 2014 | E.coli Top10-pHT3101 cry1Ac.jpg (file) |  |
1.07 MB | |
| 06:51, 18 November 2014 | E coli Top10 original.jpg (file) |  |
435 KB | |
| 06:43, 18 November 2014 | Polybt.png (file) |  |
40 KB | |
| 06:10, 18 November 2014 | Bt4q7.png (file) |  |
286 KB | |
| 06:08, 18 November 2014 | Bt 4Q7 pHTcry1Ac 74 h placa.JPG (file) |  |
960 KB | |
| 06:08, 18 November 2014 | BT 4Q7 pHTCry1Ac.png (file) |  |
305 KB | |
| 06:05, 18 November 2014 | 4Q7 48 h caldo.JPG (file) |  |
852 KB | |
| 06:02, 18 November 2014 | Phasecontrastmicro.png (file) |  |
137 KB | |
| 23:21, 13 November 2014 | Bt2.png (file) | |
275 KB | |
| 23:19, 13 November 2014 | Bt1.png (file) |  |
251 KB | |
| 05:49, 11 November 2014 | Universidaddeguanajuato.jpg (file) |  |
22 KB | |
| 04:52, 11 November 2014 | Pht3101.png (file) |  |
602 KB | |
| 02:40, 11 November 2014 | Resultado5.png (file) |  |
134 KB | |
| 02:39, 11 November 2014 | Resultado4.png (file) |  |
277 KB | |
| 02:26, 11 November 2014 | Resultado3.png (file) |  |
334 KB | |
| 02:26, 11 November 2014 | Resultado2.png (file) |  |
204 KB | |
| 02:25, 11 November 2014 | Resultados1.png (file) |  |
161 KB | |
| 02:16, 11 November 2014 | Materialesymetodos.png (file) |  |
294 KB | |
| 01:55, 11 November 2014 | Bttoxins.png (file) |  |
462 KB | |
| 01:41, 11 November 2014 | Itesm.jpg (file) |  |
93 KB | |
| 01:35, 11 November 2014 | Gel of pht3101 -Cry1Ac.png (file) |  |
665 KB | |
| 20:23, 29 October 2014 | Barbozas lab members.jpg (file) |  |
42 KB | |
| 20:04, 29 October 2014 | CabezA.jpg (file) |  |
171 KB | |
| 05:45, 29 October 2014 | Biobrickoatl.jpg (file) |  |
130 KB |